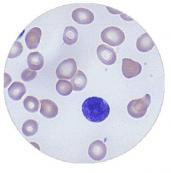

-
老年癌癥病人的急性感染
628健康網為您分享有關老年癌癥病人的急性感染的癥狀,老年癌癥病人的急性感染的治療方法,老年癌癥病人的急性感染的預防...
-
小兒肺隔離癥
628健康網為您分享有關小兒肺隔離癥的癥狀,小兒肺隔離癥的治療方法,小兒肺隔離癥的預防知識,小兒肺隔離癥的癥狀圖片,小...
-
中性粒細胞減少癥
628健康網為您分享有關中性粒細胞減少癥的癥狀,中性粒細胞減少癥的治療方法,中性粒細胞減少癥的預防知識,中性粒細胞減少...
-
中性白(粒)細胞減少癥
628健康網為您分享有關中性白(粒)細胞減少癥的癥狀,中性白(粒)細胞減少癥的治療方法,中性白(粒)細胞減少癥的預防知識,中性...
-
新生兒溶血癥
628健康網為您分享有關新生兒溶血癥的癥狀,新生兒溶血癥的治療方法,新生兒溶血癥的預防知識,新生兒溶血癥的癥狀圖片,新...
-
椎間隙感染
628健康網為您分享有關椎間隙感染的癥狀,椎間隙感染的治療方法,椎間隙感染的預防知識,椎間隙感染的癥狀圖片,椎間隙感染...
-
自身紅細胞過敏性紫癜
628健康網為您分享有關自身紅細胞過敏性紫癜的癥狀,自身紅細胞過敏性紫癜的治療方法,自身紅細胞過敏性紫癜的預防知識...
-
中性粒細胞增多癥
628健康網為您分享有關中性粒細胞增多癥的癥狀,中性粒細胞增多癥的治療方法,中性粒細胞增多癥的預防知識,中性粒細胞增多...
-
貧血伴發的精神障礙
628健康網為您分享有關貧血伴發的精神障礙的癥狀,貧血伴發的精神障礙的治療方法,貧血伴發的精神障礙的預防知識,貧血伴發...
-
嗜酸性粒細胞增多癥
628健康網為您分享有關嗜酸性粒細胞增多癥的癥狀,嗜酸性粒細胞增多癥的治療方法,嗜酸性粒細胞增多癥的預防知識,嗜酸性粒...
-
風濕病
628健康網為您分享有關風濕病的癥狀,風濕病的治療方法,風濕病的預防知識,風濕病的癥狀圖片,風濕病吃什么藥,風濕病怎么治...
-
脾亢
628健康網為您分享有關脾亢的癥狀,脾亢的治療方法,脾亢的預防知識,脾亢的癥狀圖片,脾亢吃什么藥,脾亢怎么治療,脾亢患者食...
-
組織細胞壞死性淋巴結炎
628健康網為您分享有關組織細胞壞死性淋巴結炎的癥狀,組織細胞壞死性淋巴結炎的治療方法,組織細胞壞死性淋巴結炎的預防...
-
噬血細胞綜合癥
628健康網為您分享有關噬血細胞綜合癥的癥狀,噬血細胞綜合癥的治療方法,噬血細胞綜合癥的預防知識,噬血細胞綜合癥的癥狀...
-
腦栓塞
628健康網為您分享有關腦栓塞的癥狀,腦栓塞的治療方法,腦栓塞的預防知識,腦栓塞的癥狀圖片,腦栓塞吃什么藥,腦栓塞怎么治...
-
黑熱病
628健康網為您分享有關黑熱病的癥狀,黑熱病的治療方法,黑熱病的預防知識,黑熱病的癥狀圖片,黑熱病吃什么藥,黑熱病怎么治...
-
小兒過敏性紫癜
628健康網為您分享有關小兒過敏性紫癜的癥狀,小兒過敏性紫癜的治療方法,小兒過敏性紫癜的預防知識,小兒過敏性紫癜的癥狀...
-
幼淋巴細胞白血病
628健康網為您分享有關幼淋巴細胞白血病的癥狀,幼淋巴細胞白血病的治療方法,幼淋巴細胞白血病的預防知識,幼淋巴細胞白血...
-
遺傳性抗凝血酶Ⅲ缺乏癥
628健康網為您分享有關遺傳性抗凝血酶Ⅲ缺乏癥的癥狀,遺傳性抗凝血酶Ⅲ缺乏癥的治療方法,遺傳性抗凝血酶Ⅲ缺乏癥的預防...
-
原卟啉病
628健康網為您分享有關原卟啉病的癥狀,原卟啉病的治療方法,原卟啉病的預防知識,原卟啉病的癥狀圖片,原卟啉病吃什么藥,原...
-
嬰兒期短暫性低丙球蛋白血癥
628健康網為您分享有關嬰兒期短暫性低丙球蛋白血癥的癥狀,嬰兒期短暫性低丙球蛋白血癥的治療方法,嬰兒期短暫性低丙球蛋...
-
原發性單克隆免疫球蛋白病
628健康網為您分享有關原發性單克隆免疫球蛋白病的癥狀,原發性單克隆免疫球蛋白病的治療方法,原發性單克隆免疫球蛋白病...
-
原發性皮膚免疫細胞瘤
628健康網為您分享有關原發性皮膚免疫細胞瘤的癥狀,原發性皮膚免疫細胞瘤的治療方法,原發性皮膚免疫細胞瘤的預防知識...
-
遺傳性血色病
628健康網為您分享有關遺傳性血色病的癥狀,遺傳性血色病的治療方法,遺傳性血色病的預防知識,遺傳性血色病的癥狀圖片,遺...
-
原發免疫性疾病相關的淋巴增殖性疾病
628健康網為您分享有關原發免疫性疾病相關的淋巴增殖性疾病的癥狀,原發免疫性疾病相關的淋巴增殖性疾病的治療方法,原發...
-
原發性纖維蛋白溶解癥
628健康網為您分享有關原發性纖維蛋白溶解癥的癥狀,原發性纖維蛋白溶解癥的治療方法,原發性纖維蛋白溶解癥的預防知識...
-
原發性皮膚B細胞淋巴瘤
628健康網為您分享有關原發性皮膚B細胞淋巴瘤的癥狀,原發性皮膚B細胞淋巴瘤的治療方法,原發性皮膚B細胞淋巴瘤的預防知識...
-
原發性骨髓纖維化
628健康網為您分享有關原發性骨髓纖維化的癥狀,原發性骨髓纖維化的治療方法,原發性骨髓纖維化的預防知識,原發性骨髓纖維...
-
原發性高脂蛋白血癥與黃瘤增生病
628健康網為您分享有關原發性高脂蛋白血癥與黃瘤增生病的癥狀,原發性高脂蛋白血癥與黃瘤增生病的治療方法,原發性高脂蛋...
-
中毒性高鐵血紅蛋白血癥
628健康網為您分享有關中毒性高鐵血紅蛋白血癥的癥狀,中毒性高鐵血紅蛋白血癥的治療方法,中毒性高鐵血紅蛋白血癥的預防...
-
原發性血小板減少性紫瘢
628健康網為您分享有關原發性血小板減少性紫瘢的癥狀,原發性血小板減少性紫瘢的治療方法,原發性血小板減少性紫瘢的預防...
-
遺傳性蛋白C缺陷癥
628健康網為您分享有關遺傳性蛋白C缺陷癥的癥狀,遺傳性蛋白C缺陷癥的治療方法,遺傳性蛋白C缺陷癥的預防知識,遺傳性蛋白...
-
遺傳性高鐵血紅蛋白血癥
628健康網為您分享有關遺傳性高鐵血紅蛋白血癥的癥狀,遺傳性高鐵血紅蛋白血癥的治療方法,遺傳性高鐵血紅蛋白血癥的預防...
-
遺傳性凝血因子ⅩⅢ缺乏
628健康網為您分享有關遺傳性凝血因子ⅩⅢ缺乏的癥狀,遺傳性凝血因子ⅩⅢ缺乏的治療方法,遺傳性凝血因子ⅩⅢ缺乏的預防...
-
遺傳性球形紅細胞增多癥
628健康網為您分享有關遺傳性球形紅細胞增多癥的癥狀,遺傳性球形紅細胞增多癥的治療方法,遺傳性球形紅細胞增多癥的預防...
-
遺傳性凝血因子Ⅺ缺乏
628健康網為您分享有關遺傳性凝血因子Ⅺ缺乏的癥狀,遺傳性凝血因子Ⅺ缺乏的治療方法,遺傳性凝血因子Ⅺ缺乏的預防知識...
-
幼年型慢性粒細胞白血病
628健康網為您分享有關幼年型慢性粒細胞白血病的癥狀,幼年型慢性粒細胞白血病的治療方法,幼年型慢性粒細胞白血病的預防...
-
遺傳性鐵粒幼細胞性貧血
628健康網為您分享有關遺傳性鐵粒幼細胞性貧血的癥狀,遺傳性鐵粒幼細胞性貧血的治療方法,遺傳性鐵粒幼細胞性貧血的預防...
-
原發性混合型冷球蛋白血癥性血管炎
628健康網為您分享有關原發性混合型冷球蛋白血癥性血管炎的癥狀,原發性混合型冷球蛋白血癥性血管炎的治療方法,原發性混...
-
遺傳性纖維蛋白原缺乏癥
628健康網為您分享有關遺傳性纖維蛋白原缺乏癥的癥狀,遺傳性纖維蛋白原缺乏癥的治療方法,遺傳性纖維蛋白原缺乏癥的預防...
-
幼年型粒-單核細胞白血病
628健康網為您分享有關幼年型粒-單核細胞白血病的癥狀,幼年型粒-單核細胞白血病的治療方法,幼年型粒-單核細胞白血病的預...
-
原發性巨球蛋白血癥
628健康網為您分享有關原發性巨球蛋白血癥的癥狀,原發性巨球蛋白血癥的治療方法,原發性巨球蛋白血癥的預防知識,原發性巨...
-
陣發性冷性血紅蛋白尿
628健康網為您分享有關陣發性冷性血紅蛋白尿的癥狀,陣發性冷性血紅蛋白尿的治療方法,陣發性冷性血紅蛋白尿的預防知識...
-
中樞神經系統白血病
628健康網為您分享有關中樞神經系統白血病的癥狀,中樞神經系統白血病的治療方法,中樞神經系統白血病的預防知識,中樞神經...
-
珠蛋白生成障礙性貧血
628健康網為您分享有關珠蛋白生成障礙性貧血的癥狀,珠蛋白生成障礙性貧血的治療方法,珠蛋白生成障礙性貧血的預防知識...
-
中毒性紫癜
628健康網為您分享有關中毒性紫癜的癥狀,中毒性紫癜的治療方法,中毒性紫癜的預防知識,中毒性紫癜的癥狀圖片,中毒性紫癜...
-
重癥聯合免疫缺陷
628健康網為您分享有關重癥聯合免疫缺陷的癥狀,重癥聯合免疫缺陷的治療方法,重癥聯合免疫缺陷的預防知識,重癥聯合免疫缺...
-
組織細胞增殖癥
628健康網為您分享有關組織細胞增殖癥的癥狀,組織細胞增殖癥的治療方法,組織細胞增殖癥的預防知識,組織細胞增殖癥的癥狀...
-
慢性血源性骨髓炎
628健康網為您分享有關慢性血源性骨髓炎的癥狀,慢性血源性骨髓炎的治療方法,慢性血源性骨髓炎的預防知識,慢性血源性骨髓...
-
冷球蛋白血癥
628健康網為您分享有關冷球蛋白血癥的癥狀,冷球蛋白血癥的治療方法,冷球蛋白血癥的預防知識,冷球蛋白血癥的癥狀圖片,冷...